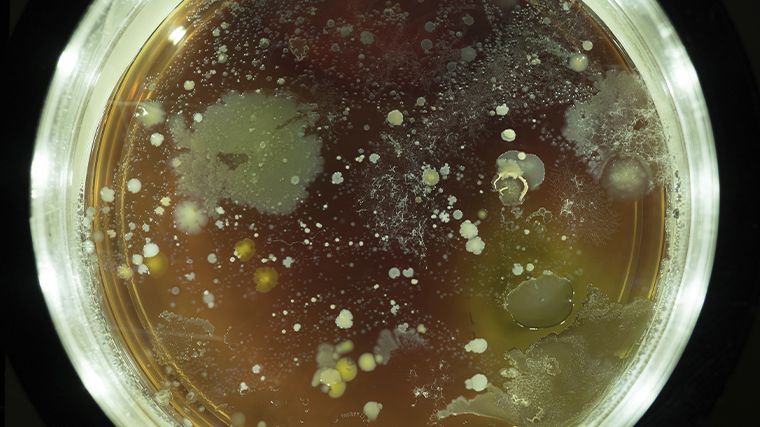

Мойте руки правильно: какие болезни вызывают грязные ладони — правила гигиены
Не помыв руки после улицы или похода в туалет, человек сильно рискует здоровьем. Повышается возможность возникновения многих болезней, включая гепатит и коронавирус.
Фото, видео: 5-tv.ru
Каждый день руки служат мостом между внешним миром и нашим организмом. Дверные ручки, поручни в метро, кнопки лифта, клавиатуры, экраны смартфонов, денежные купюры — все это поверхности, на которых живут миллионы микроорганизмов, хоть мы их и не видим. И каждое прикосновение к лицу, каждый бутерброд, съеденный на рабочем месте без дезинфекции рук, — это потенциальный риск.
Казалось бы, что может быть проще, чем вымыть руки? Но статистика неумолима: по данным Всемирной организации здравоохранения (ВОЗ), соблюдение гигиены рук способно снизить заболеваемость кишечными инфекциями более, чем на на 40%, а респираторными — почти на 25%.
Во время пандемии коронавируса человечество вновь убедилось, насколько эффективна эта простая мера. Однако даже сейчас, когда пик угрозы миновал, многие пренебрегают элементарным правилом, не осознавая, какие последствия могут скрываться за невымытыми ладонями.
Эксклюзивно 5-tv.ru семейный врач, эндокринолог, врач превентивной интегративной медицины, диетолог и нутрициолог Анастасия Самойлова рассказала и даже показала, как правильно мыть руки, чтобы защитить свое здоровье от нежелательных болячек.
Что живет на наших немытых руках
На коже рук человека и так обитает множество бактерий — это естественная микрофлора, но при контакте с загрязненными поверхностями к ним присоединяются патогенные микроорганизмы. Это и кишечная палочка, и сальмонелла, и стафилококк, и вирусы гепатита А, и ротавирусы, и обычные возбудители ОРВИ и гриппа. Некоторые из них способны сохранять жизнеспособность на поверхностях до нескольких часов или даже суток.
В 2014 году The Daily Mail опубликовала материал, в котором говорилось, что Аризонский университет провел исследование и установил, что на руках обычного человека может обитать более десяти миллионов бактерий. В то же время обычная кухонная губка содержит лишь несколько миллионов микроорганизмов.
В идеальных условиях бактерии растут стремительно, размножаясь буквально каждые 20 минут. Они могут оставаться на руках до трех часов. Особенно много их под ногтями, в складках кожи и межпальцевых промежутках.
Когда мы трогаем лицо, глаза, нос или рот, то открываем микроорганизмам прямой путь внутрь нас. Именно так начинается большинство инфекционных заболеваний, которые медики называют «болезнями грязных рук».
Какие болезни можно победить, если регулярно мыть руки
Список заболеваний, передающихся через немытые руки, поражает своим разнообразием.
Эксперт выделяет несколько «болезней немытых рук»:
- Кишечные инфекции — лидеры в этой категории. Дизентерия, сальмонеллез, эшерихиоз, ротавирусная инфекция — все они попадают в организм через рот вместе с пищей, которую мы берем немытыми руками. Особенно опасны эти инфекции для детей: обезвоживание при тяжелом течении может развиваться стремительно.
- Респираторные вирусные инфекции передаются не только воздушно-капельным путем, но и контактным. Человек с насморком прикрывает рот рукой, затем берется за поручень, а следующий пассажир касается этого поручня, а потом и своего лица. Так работают механизмы передачи гриппа, аденовирусов и коронавирусов.
- Паразитарные заболевания (гельминтозы) — еще одна группа риска. Яйца глистов могут находиться на шерсти животных, на почве, на немытых овощах и фруктах. Попадая на руки, они легко переносятся в рот. Особенно часто это случается у детей, которые тянут все в рот и не всегда помнят о гигиене.
- Инфекции слизистых оболочек — конъюнктивиты, стоматиты, герпетические высыпания — также могут быть следствием переноса бактерий с рук на лицо.
- Кожные заболевания — например, стафилококковые пиодермии, грибковые инфекции — распространяются при тесном контакте и через загрязненные руки.
Когда мыть руки обязательно

Существуют ситуации, когда гигиена рук критически необходима. Пренебрежение в этих случаях равносильно игре в русскую рулетку со своим здоровьем.
После возвращения с улицы и посещения общественных мест
Поручни эскалаторов, кнопки вызова лифта, дверные ручки магазинов — все это поверхности массового пользования. Даже если вы просто прогулялись в парке, на руки могли попасть микрочастицы почвы, содержащие бактерии.
Перед едой и приготовлением пищи
Это правило должно быть доведено до автоматизма. На кухонных поверхностях и руках часто обнаруживается кишечная палочка, которая затем попадает в готовые блюда.
В июле 2024 года «Известия» провели расследование, где оказалось, что большинство проверенных блюд от крупнейших игроков рынка в Москве оказались непригодными к употреблению.
На экспертизу отправили продукцию восьми торговых марок — это стандартные рыбные и мясные бизнес-ланчи, салаты, а также роллы. Примерно в 60% образцов, помимо ингредиентов, предусмотренных рецептом, оказалась еще кишечная палочка и другие опасные бактерии.
Такая нездоровая еда, по словам экспертов, приводит к расстройству кишечника, а также другим проблемам с желудочно-кишечным трактом. Может вызвать обострение гастрита и язвы.
После посещения туалета и смены подгузников
Фекально-оральный путь передачи инфекций — один из самых распространенных. Особенно важно соблюдать это правило при уходе за маленькими детьми.
В 2009 году было проведено исследование в Великобритании, которое показало, что у почти четверти пассажиров общественного транспорта на руках обнаружили фекальные бактерии.
После контакта с животными
Домашние питомцы могут быть носителями гельминтов и бактерий, а уличные животные — тем более. Даже если кошка или собака кажутся чистыми, на их шерсти могут находиться яйца паразитов.
После кашля, чихания, сморкания
Выделения из носа и рта содержат огромное количество вирусов и бактерий. Если вы прикрывали рот рукой, на ней осели возбудители, которые готовы отправиться дальше — на дверные ручки, телефон, лицо.
После уборки помещения и контакта с мусором
В мусорных ведрах размножаются гнилостные бактерии и плесневые грибы. Даже если вы надевали перчатки, после их снятия руки лучше вымыть.
До и после ухода за больным или пожилым человеком
Люди с ослабленным иммунитетом особенно уязвимы перед инфекциями. Принося на руках бактерии извне, вы можете навредить тому, о ком заботитесь.
Как правильно мыть руки

Казалось бы, что сложного — намылить руки и смыть? Но исследования показывают: большинство людей моют руки неправильно, уделяя процессу меньше десяти секунд и пропуская важные зоны.
Оказывается, даже такая простая и привычная процедура, как мытье рук, вызывает у людей массу сложностей, когда дело касается рабочей обстановки. Исследование, проведенное по заказу национального поставщика туалетных услуг и опубликованное в Safety and Health Practitioner в 2021 году, выявило удручающую тенденцию: большинство британцев пренебрегают элементарными правилами гигиены, находясь на своих рабочих местах.
Цифры, мягко говоря, впечатляют. Более половины опрошенных сотрудников, а именно 55%, моют руки меньше рекомендованных ВОЗ 20 секунд. При этом каждый четвертый и вовсе укладывается в смешные десять секунд или даже меньше.
Всего 37% опрошенных честно признались, что тратят на гигиеническую процедуру положенные 20 секунд и более. Что характерно, самыми сознательными в этом вопросе оказались люди старше 55 лет — почти половина из них соблюдают рекомендуемое время мытья.
Но на этом проблемы не заканчиваются — 57% британцев покидают рабочий туалет с мокрыми руками. Главная причина — недовольство местным сушильным оборудованием, которое, по мнению сотрудников, работает недостаточно хорошо или слишком медленно.
Лишь 31% респондентов заявили, что всегда выходят из рабочего туалета с сухими руками. Для сравнения, дома ту же самую ванную комнату с сухими руками покидают уже 66% опрошенных.
Между тем техника мытья рук разработана не случайно — она учитывает анатомию и особенности загрязнения разных участков.
ВОЗ рекомендует следующий алгоритм:
- Смочите руки теплой проточной водой: она не должна быть обжигающей — слишком горячая сушит кожу и может вызвать раздражение. Холодная вода хуже справляется с растворением жировых загрязнений;
- Нанесите мыло. Жидкое мыло предпочтительнее кускового, так как на поверхности кускового могут оставаться бактерии. Но если вы пользуетесь первым вариантом, важно хранить его в мыльнице, позволяющей воде стекать;
- Вспеньте мыло, распределяя по всей поверхности кистей. Тщательно намыльте ладони и тыльную сторону кистей;
- Уделите внимание межпальцевым промежуткам. Пальцы переплетаются, и круговыми движениями промываются участки между пальцами — сначала на одной руке, потом на другой;
- Особое внимание — большим пальцам, именно их часто забывают, а между тем большой палец контактирует с большинством предметов. Обхватите его ладонью другой руки и вращательными движениями промойте со всех сторон;
- Обработайте кончики пальцев. Сомкните пальцы в замок и потрите подушечками о ладони — под ногтями скапливается больше всего грязи;
- Не забывайте о запястьях, ведь на них также оседают микроорганизмы, особенно если вы носите часы или браслеты;
- Смывайте мыло под струей воды. Делайте это так, чтобы вода стекала от запястий к кончикам пальцев — это предотвращает повторное загрязнение чистых участков;
- Тщательно высушите руки, потому что влажная кожа — идеальная среда для размножения бактерий. Используйте чистое полотенце (меняйте его каждые два-три дня) или одноразовые бумажные салфетки.
«Запомнить необходимое время мытья рук легко: пропойте дважды песню „Happy Birthday“ или считайте про себя до двадцати», — советует эксперт.
Когда можно позволить себе не мыть руки

Однако в жизни каждого человека случаются ситуации, когда строгое следование этому правилу может быть избыточным или попросту невозможным. Разумеется, речь не идет о сознательном пренебрежении чистотой, а лишь об обстоятельствах, в которых умеренная осторожность вполне уместна.
Прежде всего, стоит обратить внимание на домашнюю обстановку. Если вы находитесь в своей квартире или доме в течение непродолжительного времени и при этом не контактировали с уличными вещами — верхней одеждой, обувью, сумками или пакетами из магазина, — то навязчивое мытье рук каждые полчаса действительно не обязательно. В замкнутом и чистом пространстве, где живут только близкие люди, риск подхватить инфекцию с поверхностей минимален.
Еще одна допустимая ситуация — работа за компьютером или выполнение домашних заданий при условии, что руки были недавно очищены. Если вы сели за стол после душа или тщательного мытья, а в процессе касаетесь только клавиатуры, мыши или книг, до которых до этого дотрагивались только вы, — повода для внеочередного похода в ванную нет.
Однако здесь важно помнить о так называемом правиле «чистых рук»: как только вы отвлеклись на телефон, взяли в руки пульт от телевизора или почесали кота, отсчет начинается заново.
Особого разговора заслуживает активный отдых на природе. Пикники, походы, дачные работы или выезды на шашлыки часто проходят в условиях ограниченного доступа к воде. Таскать за собой ведро или постоянно бегать к далекому умывальнику попросту невозможно.
В таких ситуациях на помощь приходят антисептические средства: специальные салфетки, гели или спреи для рук на спиртовой основе. Они не заменяют полноценного мытья с мылом, но позволяют эффективно снизить количество бактерий до тех пор, пока не появится возможность вымыть руки по-настоящему.
Все перечисленные случаи — это скорее исключения, чем правила. Врачи и эпидемиологи сходятся во мнении, что гораздо разумнее перестраховаться и промыть руки лишний раз, чем потом бороться с последствиями пренебрежения гигиеной.
Как правильно выбрать антисептик для рук

Роспотребнадзор выпустил подробные рекомендации, как не ошибиться с выбором антисептика и действительно обезопасить себя, а не просто выбросить деньги на ветер.
Любой качественный кожный антисептик в России обязан иметь свидетельство о государственной регистрации.
Номер этого документа всегда указывают на упаковке, и его легко проверить через открытые реестры. Если производитель пишет, что его продукт убивает коронавирус, стоит поискать подтверждение, иначе это просто рекламный трюк.
Что касается состава, то золотой стандарт здесь — спирт. Лучше всего выбирать средства на основе этилового или изопропилового спирта. Именно они способны быстро и надежно уничтожать вирусы и бактерии.
Если в составе смесь спиртов, важно, чтобы их суммарная доля была достаточной — и здесь нужно смотреть на показатель «по массе». Некоторые антисептики дополнительно содержат глицерин или другие смягчающие добавки, чтобы кожа не пересыхала.
Но даже самое хорошее средство не сработает, если использовать его неправильно. На упаковке всегда должно быть написано, сколько антисептика наносить и сколько времени выдерживать. Это принципиальный момент, потому что спирту нужно время, чтобы подействовать.
Если вы целый день сидите дома и не контактируете с улицей, бесконечно обрабатывать руки необязательно. А вот если пользуетесь общественным транспортом, трогаете деньги, дверные ручки или офисную клавиатуру, тут без антисептика не обойтись.
Наконец, важно заглянуть в состав и убедиться, что там нет агрессивных кислот или альдегидов. Такие компоненты могут навредить коже и точно не нужны в повседневном средстве гигиены.
Как мытье рук спасло жизни роженицам

Сегодня мы воспринимаем гигиену как должное, но еще 150 лет назад врачи могли переходить от вскрытия трупов к приему родов, не помыв руки.
Когда в 1846 году венгерский акушер Игнац Земмельвейс начал работать в первом отделении венской клиники, том самом, где обучали студентов-медиков, он сразу заметил неладное.
Смертность в этом «научном» отделении была в пять раз выше, чем во втором, где принимали роды акушерки. При этом условия содержания были одинаковыми. Еда поступала с одной кухни, белье стирали в одной прачечной, здание проветривалось в одно и то же время.
Разница была только в одном — в первом отделении работали молодые врачи, которые по утрам практиковались на трупах в морге, а затем, без достаточной гигиены, шли к живым женщинам. А они потом умирали.
Женщины умирали от одного и того же — заражения кровотока трупными частицами. А эти частицы на руках переносили врачи — те самые, кто наутро делал вскрытия, а днем принимал роды. Эта гипотеза все объясняла.
В отделении акушерок, не допускавшихся к трупам, смертей почти не было. А в отделении врачей — десятки, сотни. Иногда роженицу осматривали по 15 студентов подряд, каждый со своими немытыми руками, каждый невольно становился палачом.
Да, врачи теоретически мыли руки. Иногда просто теплой водой, иногда вытирали платком. Убедившись в своей догадке, Земмельвейс пошел дальше. Он начал искать средство, которое надежно убьет все следы трупного вещества. Остановился на растворе хлора.
С этого момента ни один студент не имел права осматривать пациентку, не вымыв руки в хлорной воде. И случилось чудо. Всего за полгода смертность от родильной горячки в клинике упала с 12% до 3%.
В 1848 году произошел беспрецедентный случай, когда в марте и августе не умерла ни одна роженица. Болезнь, которая уносила жизни десятков женщин ежемесячно, отступила. Казалось бы — победа. Но не тут-то было.
Земмельвейс не спешил с научными публикациями. Он не стремился к славе, не произносил торжественных речей, не выступал на конференциях. Открытие он обсуждал в кругу друзей. Возможно, ему не хватало уверенности, возможно, свободного владения немецким языком, чтобы донести свои мысли до международного сообщества. В итоге за него доклады делали другие. А сам он лишь рассылал письма коллегам с просьбой попробовать метод.
В итоге открытие, которое могло моментально изменить акушерство во всей Европе, было отодвинуто на задний план. А его автор был на годы забыт. Земмельвейс сделал шаг вперед, но мир не был готов за ним последовать.
Игнац Земмельвейс был не только выдающимся врачом, но и борцом за правду. В 1848 году он участвовал в венгерском восстании и вошел в оппозиционную «академическую лигу», что стоило ему карьеры.
После окончания ординатуры в Вене в 1849 году контракт с ним не продлили, несмотря на поддержку коллег. В 1850 году он получил место доцента, но с ограничениями. Тогда ему запретили работать с реальными пациентами. Через несколько дней он покинул Вену, не попрощавшись ни с кем. В Будапеште Земмельвейс устроился в небольшую женскую больницу. Увидев ужасающие условия и высокую смертность, он немедленно навел порядок и внедрил гигиенические меры.
В результате за пять лет было всего восемь смертей от родильной лихорадки среди 933 рожениц. Вдохновленный успехом, он написал монографию. Но вместо взвешенной научной работы получилось агрессивное обвинение коллег в убийствах.
В письмах врачам Европы Земмельвейс называл их невежественными и тщеславными, что только усилило его изоляцию. Его прозвали «диким венгром» и «будапештским сумасшедшим». С возрастом его психическое состояние ухудшилось.
В 1865 году его тайно поместили в психиатрическую клинику, где он умер спустя две недели, предположительно, от побоев. Ему было 47 лет.
Ирония судьбы в том, что признание пришло слишком поздно. Методы Земмельвейса вскоре подтвердили Луи Пастер и Джозеф Листер. Его идеи легли в основу современной антисептики, а сам он остался в истории как спаситель матерей.
Читайте также
749 мм рт. ст.
93%